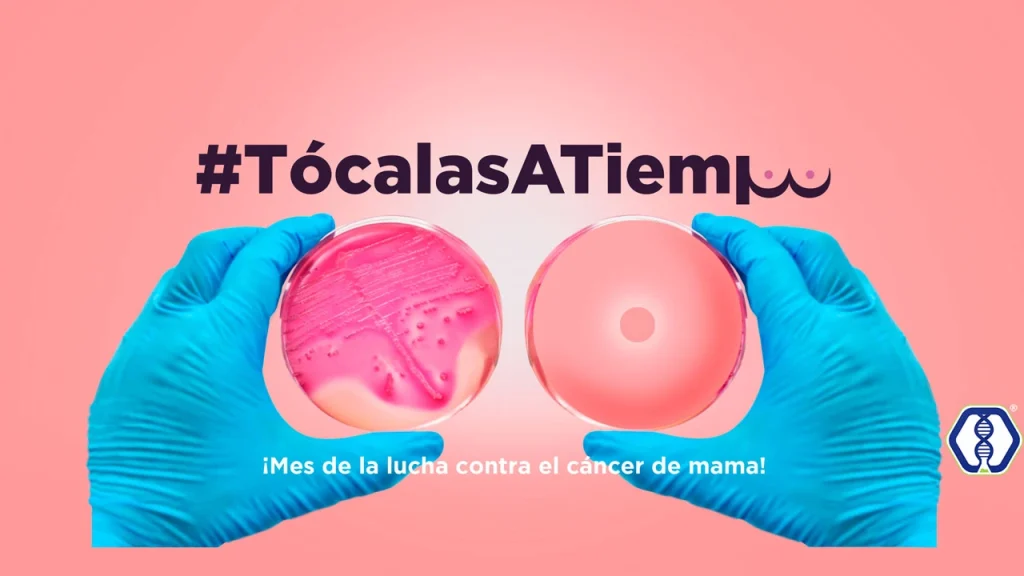

¡Mujer, tocar tus mamas puede salvar tu vida! La autoexploración es una técnica de detección y prevención que consiste en una revisión de las mamas, a través del tacto realizado por la misma mujer.
En la actualidad existen muchas herramientas para prevenir el cáncer de mama, una de las más antiguas y que sigue teniendo un auge importante es la autoexploración, la cual es recomendable que se realice una vez al mes a partir de los 20 años de edad.
Si aún no sabes cómo hacerla, te compartimos una guía sencilla e ilustrada del paso a paso.
Otras formas de prevención:
Actividad física y buena alimentación.
Evita el consumo de tabaco y bebidas alcohólicas.
Visita a tu médico o ginecólogo de forma frecuente.
Si presentas alguna anomalía, recuerda siempre consultar a tu médico.